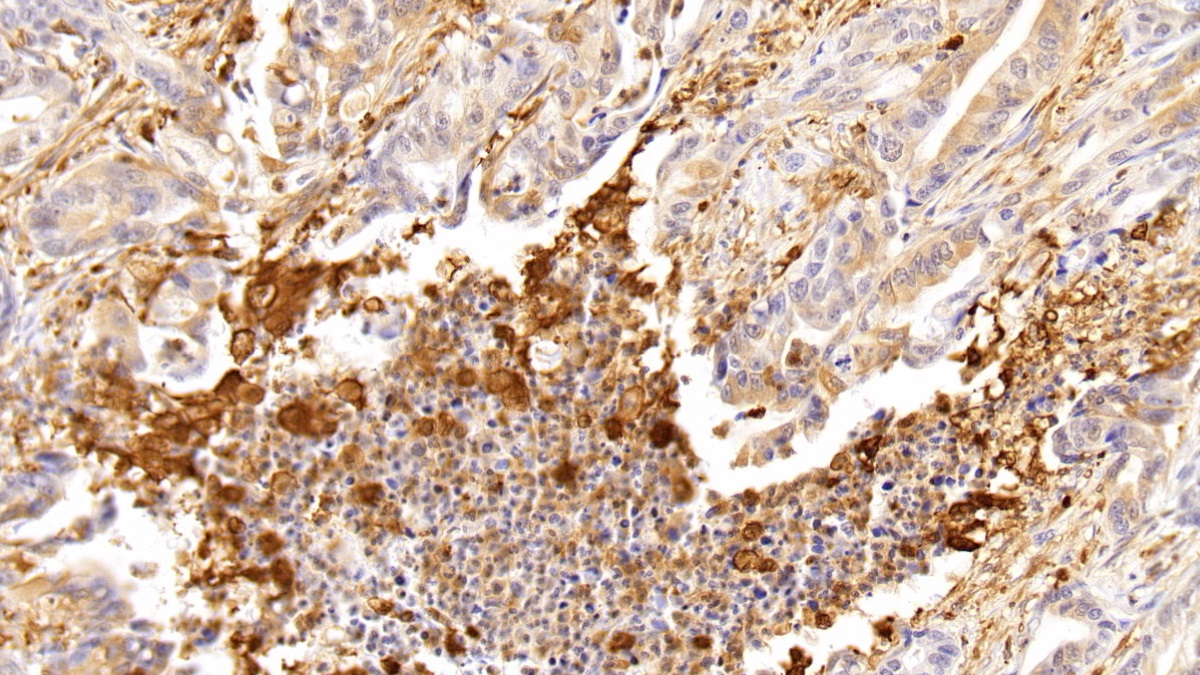

Polyclonal Antibody to Tumor Protein p53 (P53)
TP53; LFS1; TRP53; Li-Fraumeni Syndrome; Cellular tumor antigen p53; Antigen NY-CO-13; Phosphoprotein p53; Tumor suppressor p53
- Product No.PAA928Hu02
- Organism SpeciesHomo sapiens (Human) Same name, Different species.
- SourcePolyclonal antibody preparation
- HostRabbit
- Potencyn/a
- Ig Type IgG
- PurificationAntigen-specific affinity chromatography followed by Protein A affinity chromatography
- LabelNone
- Immunogen RPA928Hu02-Recombinant Tumor Protein p53 (P53)
- Buffer FormulationPBS, pH7.4, containing 0.02% NaN3, 50% glycerol.
- TraitsLiquid
- Concentration0.5mg/mL
- Organism Species Moren/a
- ApplicationsWB; IHC; FCM
If the antibody is used in flow cytometry, please check FCM antibodies. - DownloadInstruction Manual
- UOM 20µl100µl 200µl 1ml 10ml
- FOB
US$ 98
US$ 229
US$ 327
US$ 818
US$ 3270
For more details, please contact local distributors!
SPECIFITY
The antibody is a rabbit polyclonal antibody raised against P53. It has been selected for its ability to recognize P53 in immunohistochemical staining and western blotting.
USAGE
Western blotting: 0.01-2µg/mL;
Immunohistochemistry: 5-20µg/mL;
Flow cytometry: 20µg/mL;
Optimal working dilutions must be determined by end user.
STORAGE
Store at 4°C for frequent use. Stored at -20°C in a manual defrost freezer for two year without detectable loss of activity. Avoid repeated freeze-thaw cycles.
STABILITY
The thermal stability is described by the loss rate. The loss rate was determined by accelerated thermal degradation test, that is, incubate the protein at 37°C for 48h, and no obvious degradation and precipitation were observed. The loss rate is less than 5% within the expiration date under appropriate storage condition.
GIVEAWAYS
INCREMENT SERVICES
-
 Antibody Labeling Customized Service
Antibody Labeling Customized Service
-
 Protein A/G Purification Column
Protein A/G Purification Column
-
 Staining Solution for Cells and Tissue
Staining Solution for Cells and Tissue
-
 Positive Control for Antibody
Positive Control for Antibody
-
 Tissue/Sections Customized Service
Tissue/Sections Customized Service
-
 Phosphorylated Antibody Customized Service
Phosphorylated Antibody Customized Service
-
 Western Blot (WB) Experiment Service
Western Blot (WB) Experiment Service
-
 Immunohistochemistry (IHC) Experiment Service
Immunohistochemistry (IHC) Experiment Service
-
 Immunocytochemistry (ICC) Experiment Service
Immunocytochemistry (ICC) Experiment Service
-
 Flow Cytometry (FCM) Experiment Service
Flow Cytometry (FCM) Experiment Service
-
 Immunoprecipitation (IP) Experiment Service
Immunoprecipitation (IP) Experiment Service
-
 Immunofluorescence (IF) Experiment Service
Immunofluorescence (IF) Experiment Service
-
 Buffer
Buffer
-
 DAB Chromogen Kit
DAB Chromogen Kit
-
 SABC Kit
SABC Kit
-
 Long-arm Biotin Labeling Kit
Long-arm Biotin Labeling Kit
-
 Real Time PCR Experimental Service
Real Time PCR Experimental Service
| Magazine | Citations |
| Anticancer Research | Analysis of p53 and miRNA expression after irradiation of glioblastoma cell lines PubMed: 23155233 |
| Microscopy Research and Technique | Therapeutic role of curcumin in oxidative DNA damage caused by formaldehyde PubMed: 25761397 |
| J Nutr Biochem | Supplementation with Selenium yeast on the prooxidant–antioxidant activities and anti-tumor effects in breast tumor xenograft-bearing mice PubMed: 26344777 |
| Biochemical and Biophysical Research Communications | Transcription factor HBP1: A regulator of senescence and apoptosis of preadipocytes Pubmed: 31331641 |
| Folia Biologica | Effect of Graviola (Annona Muricata l.) and Ginger (Zingiber Officinale Roscoe) on Diabetes Mellitus Induced in Male Wistar Albino Rats |
| Non-POU Domain-Containing Octamer-Binding (NONO) Protein Stability Regulated by PIN1 is Crucial for Breast Cancer Tumorigenicity Via the MAPK/β … |